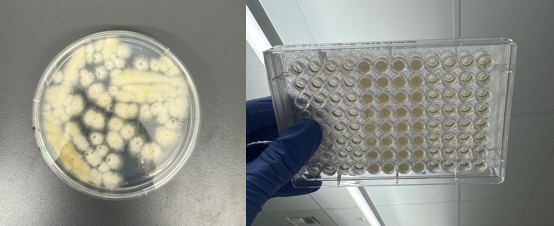
微信圖片_20251219131633_532_102.png

新聞應(yīng)用
更新時(shí)間:2025-12-19 瀏覽次數(shù):320
從大腸桿菌到絲狀真菌,能不能挑?答案是絕對(duì)肯定!微生物家族形態(tài)萬(wàn)千,有的色彩艷麗、黏附性強(qiáng),有的呈絲狀發(fā)散、形態(tài)不規(guī)則,有的則微小纖細(xì)難以捕捉。自 2017 年 PIXL 挑菌工作站問(wèn)世以來(lái),科研人員已用它成功挑戰(zhàn)了數(shù)十種模式生物與非模式生物,從經(jīng)典細(xì)菌、酵母到絲狀真菌、真核藻類(lèi),其兼容能力不斷刷新行業(yè)認(rèn)知。
作為專(zhuān)為核心微生物研發(fā)的高通量挑取設(shè)備,PIXL 對(duì)大腸桿菌(E. coli)和釀酒酵母(S. cerevisiae)的轉(zhuǎn)移效率早已得到行業(yè)驗(yàn)證。而如今,越來(lái)越多前沿研究證明,它的 “挑取版圖” 已覆蓋更廣泛的微生物領(lǐng)域,以下最新案例將直觀展現(xiàn)其強(qiáng)大的適配能力。

經(jīng)典模式生物:
高通量篩選的 “黃金搭檔”
01 大腸桿菌(Escherichia coli)/
生物醫(yī)學(xué)研究的 “常青樹(shù)”
自20世紀(jì)40年代成為模式生物以來(lái),大腸桿菌仍是分子生物學(xué)、蛋白質(zhì)工程的核心研究對(duì)象。斯坦福大學(xué)生物工程系的科研團(tuán)隊(duì)借助PIXL的高通量?jī)?yōu)勢(shì),在15厘米大培養(yǎng)皿(單皿最大容納500個(gè)菌落)中快速篩選突變型大腸桿菌,精準(zhǔn)挑取目標(biāo)菌落并轉(zhuǎn)移至384孔板。這一技術(shù)突破不僅優(yōu)化了蛋白質(zhì)突變體文庫(kù)的制備流程,更助力團(tuán)隊(duì)深入解析了突變體的生物化學(xué)特性,為酶工程與藥物研發(fā)提供了高效工具。

斯坦福大學(xué)科學(xué)家利用PIXL支持開(kāi)發(fā)一種可擴(kuò)展、且高度清晰的克隆突變體庫(kù)創(chuàng)建方法
02. 釀酒酵母(Saccharomyces cerevisiae)/
遺傳學(xué)研究的 “精準(zhǔn)利器”
當(dāng)PIXL與MSM 400聯(lián)用,科研人員首次實(shí)現(xiàn)了釀酒酵母四分體解剖菌落的高通量分析,徹底擺脫了傳統(tǒng)手動(dòng)操作的低效率瓶頸。Singer Instruments長(zhǎng)期與酵母遺傳學(xué)專(zhuān)家合作,深耕單細(xì)胞精確操作技術(shù),斯特拉斯堡大學(xué)團(tuán)隊(duì)他們利用 PIXL分析釀酒酵母 1011基因組集合中的106個(gè)自然分離株,系統(tǒng)探究了不同遺傳背景下突變體的環(huán)境適應(yīng)性差異。該研究首次證實(shí) “相同突變?cè)诓煌z傳背景下表現(xiàn)異質(zhì)性” 的普遍規(guī)律,為人類(lèi)復(fù)雜疾病的遺傳機(jī)制研究提供了重要參考。
非模式微生物:
工業(yè)應(yīng)用與前沿探索的 “破局者”
01. 野生酵母 /
發(fā)酵行業(yè)的 “優(yōu)質(zhì)菌株挖掘師”
盡管實(shí)驗(yàn)室釀酒酵母仍是主力,但非釀酒酵母菌株在發(fā)酵行業(yè)的應(yīng)用潛力日益凸顯。曼徹斯特生物技術(shù)研究所團(tuán)隊(duì),借助PIXL高通量篩選套件,從全球各地的極端環(huán)境(啤酒廠、夏威夷樹(shù)木、德國(guó)小蠊、美國(guó)伊利諾伊州奶油制品)分離出的23種酵母菌株(6種傳統(tǒng)型+17種非傳統(tǒng)型)中,精準(zhǔn)篩選蘋(píng)果酒發(fā)酵專(zhuān)用優(yōu)質(zhì)菌株。
研究團(tuán)隊(duì)通過(guò)PIXL將酵母文庫(kù)重新整理為96孔、384孔及1536孔固體瓊脂陣列,再經(jīng) ROTOR+在工業(yè)模擬條件下進(jìn)行文庫(kù)復(fù)制,最終由Phenobooth+以像素級(jí)精度記錄不同時(shí)間點(diǎn)的菌落半徑數(shù)據(jù)。這套一體化方案大幅提升了工業(yè)菌株篩選效率,為未知分離株的文庫(kù)篩選提供了標(biāo)準(zhǔn)化流程。

曼徹斯特生物技術(shù)研究所的研究人員利用ROTOR+PIXL 技術(shù),在模擬工業(yè)條件的固體培養(yǎng)基中重新排列并復(fù)制了大量的釀酒酵母和非釀酒酵母分離株。
02. 其他原核生物 /
微生物鑒定的 “自動(dòng)化賦能者”
Singer Instruments與島津(Shimadzu)的跨界合作,驗(yàn)證了PIXL在原核生物領(lǐng)域的廣泛兼容性。雙方聯(lián)合開(kāi)發(fā)的MALDI-TOF樣品自動(dòng)化制備方案,不僅適用于大腸桿菌,更成功應(yīng)對(duì)了枯草芽孢桿菌(Bacillus subtilis)、纖維單胞菌(Cellulomonas uda)、成團(tuán)泛菌(Pantoea agglomerans)等多種原核生物。該方案通過(guò)提升菌落轉(zhuǎn)移的穩(wěn)定性與效率,顯著提高了細(xì)菌鑒定的準(zhǔn)確性,為臨床微生物檢測(cè)、環(huán)境微生物分析提供了高效解決方案。

03. 萊茵衣藻(Chlamydomonas reinhardtii)
真核藻類(lèi)的 “基因工程利器”
作為植物總界的新型遺傳模式生物,萊茵衣藻具有黏附性強(qiáng)、呈綠色、細(xì)胞大小與生長(zhǎng)特性異于酵母的特點(diǎn),傳統(tǒng)挑取設(shè)備難以應(yīng)對(duì)。阿卜杜拉國(guó)王科技大學(xué)(KAUST)研究團(tuán)隊(duì)打破了這一限制:他們將PIXL與ROTOR+聯(lián)用,開(kāi)發(fā)出基因工程藻類(lèi)的低成本生物工藝,更利用PIXL的熒光篩選功能,精準(zhǔn)挑取表達(dá)紅色 / 黃色熒光蛋白的菌落,成功優(yōu)化異戊二烯生產(chǎn)菌株。這項(xiàng)研究不僅彰顯了 PIXL 的適配能力,更為環(huán)保型橡膠生產(chǎn)提供了新路徑。

04. 絲狀真菌
生物勘探的 “突破性工具”
絲狀真菌因形態(tài)發(fā)散、易污染,一直是自動(dòng)挑取的難點(diǎn)。當(dāng)兩家生物勘探公司提出測(cè)試需求時(shí),Singer Instruments成功用PIXL攻克挑戰(zhàn):針對(duì)具有抗真菌價(jià)值的深棕色絲狀真菌洛佐瓦類(lèi)綠僵菌(Glarea lozoyensis),PIXL實(shí)現(xiàn)了無(wú)污染挑??;在黑曲霉(Aspergillus niger)和構(gòu)巢曲霉(Aspergillus nidulans)的初步測(cè)試中,借助獨(dú)特的 “干混技術(shù)”(挑取頭輕劃菌落即可完成取樣,無(wú)需上下穿刺),56個(gè)測(cè)試菌落的成功挑取率達(dá)98.4%(見(jiàn)圖 2)。盡管仍需更多對(duì)照試驗(yàn)積累數(shù)據(jù),但這一結(jié)果已為絲狀真菌的高通量篩選開(kāi)辟了新可能。

PIXL獨(dú)特的“干混”能力能夠采摘曲霉及其他絲狀植物
PIXL的 “挑取法則” 與無(wú)限潛力
上述案例僅為PIXL眾多成功應(yīng)用的冰山一角,卻足以印證其 “微生物全能挑取者” 的定位。根據(jù)Singer的實(shí)踐經(jīng)驗(yàn),PIXL的核心優(yōu)勢(shì)在于:只要手動(dòng)可挑取(無(wú)需過(guò)度用力或深度挖掘)的菌落,它都能實(shí)現(xiàn)高效、精準(zhǔn)、無(wú)污染的自動(dòng)化轉(zhuǎn)移,此外,PIXL已全面適配IPAN厭氧工作站,A-PIXL可提供適配的厭氧外罩來(lái)滿(mǎn)足全程厭氧環(huán)境挑菌的實(shí)驗(yàn)需求。
從經(jīng)典模式生物到極端環(huán)境分離株,從細(xì)菌、酵母到藻類(lèi)、絲狀真菌,PIXL不斷突破微生物挑取的邊界,為科研與工業(yè)應(yīng)用提供了標(biāo)準(zhǔn)化、高通量的解決方案。如果你正面臨特殊形態(tài)微生物的挑取難題,歡迎聯(lián)系我們,親自驗(yàn)證PIXL的實(shí)力!
關(guān)于我們
聯(lián)系我們

?2024 上海磐麥科技有限公司 版權(quán)所有 備案號(hào):滬ICP備20012062號(hào)-3